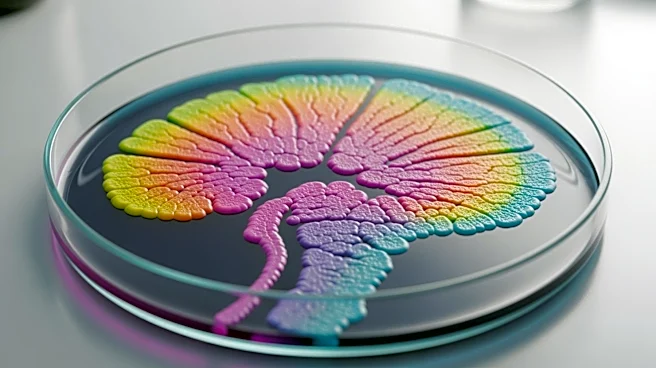

What's Happening?
Recent studies have investigated the role of gut microbiomes in influencing dietary preferences. Researchers Kevin Kohl and Brian Trevelline conducted experiments by transplanting microbiomes from wild rodents into germ-free mice, observing changes in their
food choices. The study revealed that mice with herbivore microbiomes preferred protein, while those with carnivore microbiomes leaned towards carbohydrates. Additionally, a 2025 study published in Nature Microbiology found that the bacterium Bacteroides vulgatus can suppress sugar cravings in mice, potentially offering therapeutic avenues for managing type 2 diabetes. These findings suggest that gut bacteria may play a significant role in shaping dietary preferences and appetite regulation.
Why It's Important?
Understanding the influence of microbiomes on dietary preferences could have significant implications for human health, particularly in managing conditions like type 2 diabetes. The ability of certain gut bacteria to suppress sugar cravings highlights potential therapeutic strategies that could be developed to regulate appetite and improve metabolic health. This research also underscores the complex relationship between diet and microbiome composition, suggesting that small dietary changes could have long-term effects on health. As the study connects microbiome findings to human health, it opens new avenues for personalized nutrition and dietary interventions.
What's Next?
Further research is needed to explore the applicability of these findings to human dietary behaviors, considering the influence of cultural, societal, and economic factors. Scientists may investigate how microbiome manipulation could be used in clinical settings to manage dietary preferences and metabolic disorders. Additionally, the development of microbiome-based therapies could become a focus for pharmaceutical companies aiming to address obesity and diabetes. As the field progresses, collaborations between microbiologists, nutritionists, and healthcare providers will be crucial in translating these findings into practical health solutions.
Beyond the Headlines
The ethical implications of manipulating microbiomes to alter dietary preferences warrant consideration. While the potential health benefits are promising, the long-term effects of such interventions on human behavior and health need thorough evaluation. Additionally, the commercialization of microbiome-based therapies could raise questions about accessibility and equity in healthcare. As research advances, it will be important to balance innovation with ethical responsibility, ensuring that new treatments are safe, effective, and available to all who need them.